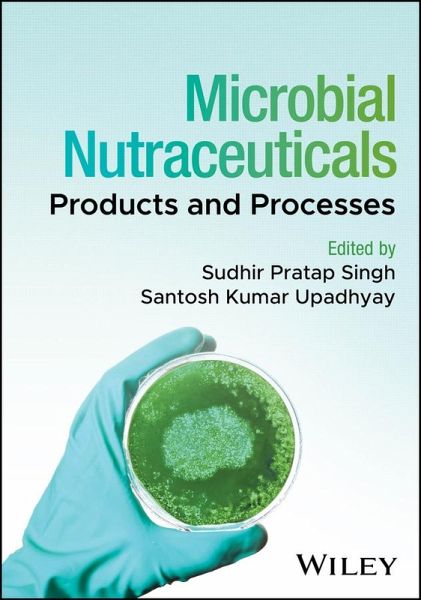
Microbial Nutraceuticals (eBook, PDF)

Microbial Nutraceuticals (eBook, PDF)
Products and Processes
Redaktion: Singh, Sudhir Pratap; Upadhyay, Santosh Kumar
Versandkostenfrei!
Sofort per Download lieferbar
157,99 €
inkl. MwSt.
Weitere Ausgaben:
PAYBACK Punkte
0 °P sammeln!
An exploration of the latest advances in the application of microbial nutraceuticals in healthcare, food production, and agricultureIn Microbial Nutraceuticals: Products and Processes, a team of distinguished researchers delivers an up-to-date and authoritative discussion of the recent advances in the application of microbial nutraceuticals and their implementation in the health, food, and agriculture sectors. The book begins with an overview of microbial nutraceuticals before moving on to discussions of more specific topics, including microbial cell factories for the production of essential a...
An exploration of the latest advances in the application of microbial nutraceuticals in healthcare, food production, and agriculture
In Microbial Nutraceuticals: Products and Processes, a team of distinguished researchers delivers an up-to-date and authoritative discussion of the recent advances in the application of microbial nutraceuticals and their implementation in the health, food, and agriculture sectors. The book begins with an overview of microbial nutraceuticals before moving on to discussions of more specific topics, including microbial cell factories for the production of essential amino acids, microbial production of dietary short-chain fatty acids, and microbial sources for bioactive peptides conferring health benefits.
Readers will also find:
This book is intended for academics, scientists, and researchers working in the field of microbial nutraceuticals. Additionally, it will benefit professionals working in the agri-biotech industries, as well as graduate and post-graduate students with an interest in the subject.
In Microbial Nutraceuticals: Products and Processes, a team of distinguished researchers delivers an up-to-date and authoritative discussion of the recent advances in the application of microbial nutraceuticals and their implementation in the health, food, and agriculture sectors. The book begins with an overview of microbial nutraceuticals before moving on to discussions of more specific topics, including microbial cell factories for the production of essential amino acids, microbial production of dietary short-chain fatty acids, and microbial sources for bioactive peptides conferring health benefits.
Readers will also find:
- A thorough introduction to symbiotic products with nutraceutical impact
- Comprehensive explorations of postbiotic supplements with nutraceutical significance
- Practical discussions of microbial production of carotenoids
- Complete treatments of microbial engineering for multivitamin production
This book is intended for academics, scientists, and researchers working in the field of microbial nutraceuticals. Additionally, it will benefit professionals working in the agri-biotech industries, as well as graduate and post-graduate students with an interest in the subject.
Dieser Download kann aus rechtlichen Gründen nur mit Rechnungsadresse in D ausgeliefert werden.